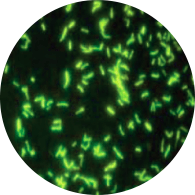
Mycobacteria in Fluorescent Microscopy

Mycobacterium tuberculosis(MTB) is the causative agent of tuberculosis (TB) in humans. It is a slightly curved rod arranged singly or in groups. Mycobacterium tuberculosis grows very slowly, taking up to 6 weeks for visible growth. The cell wall of Mycobacteria contains mycolic acid and gives acid-fastcharacteristics.
Robert Koch named the organismM.tuberculosisin 1886.

Sample: Sputum, BAL, urine (in renal tuberculosis), blood, fluids, tissue, and gastric lavage (in case of children). The use of samples may be either directly (as in case of body fluids which is sterile) or after decontamination (as in sputum which is unsterile). Some samples are concentrated before use for culture, animal inoculation, and sometimes to yield better results in microscopy.
Direct Detection of Actively Growing Bacilli
Direct detection of infection includes microscopy, culture, antigen detection, and nucleic acid detection.
Microscopy

Microscopy is the most rapid diagnostic method for the detection of tubercle bacilli. Standard light microscopy and fluorescent microscopy are commonly used for detection. In light microscopy, M.tuberculosis appears as red-pink long or slightly curved bacilli when stained by AFB staining (Ziehl-Neelsen stain).
The acid-fast stain has low sensitivity; approximately 50% of “smear-negative” samples are found to be “culture-positive.”
When using fluorescent microscopy,****acid-fast organisms will appear yellow or orange under ultraviolet light when stained with rhodamine auramine stain and bright orange fluorescing bacilli in a pale green background when stained by acridine orange.
Culture
Culture is a more sensitive method for the detection of tubercle bacilli and is necessary for performing antimicrobial drug sensitivity testing and genotyping.

After digestion of the specimen by treatment with NaOH and concentration by centrifugation, the sample is inoculated into a protein-rich medium (such as Lowenstein-Jensen mediumor Middlebrook medium) and incubated at 37°C for up to 8 weeks. M.tuberculosis shows dry, rough, creamy, or buff-colored colonies in Löwenstein–Jensen medium.
On liquid medium, tubercle bacilli grow on the surface and form a wrinkled pellicle.
Mycobacteria grow more rapidly and reliably in a liquid culture medium compared with the solid medium.
If inoculated in BACTEC culture medium growth is detected by the production of radioactive carbon dioxide in about 2 weeks.
Presumptive colonies from culture medium are further identified by biochemical tests such as niacin test, nitrate reductase test, tween 80 hydrolysis, arylsulfatase test, and urease test. M.tuberculosis shows positive niacin, nitrate reduction, and urease test.
Molecular Diagnosis
Because of the slow growth rate of the M. tuberculosiscomplex (MTBC) bacilli, molecular techniques have become the cornerstone for the rapid detection of TB.
Nucleic Acid Amplification Tests (NAAT)
The nucleic acid amplification tests (NAAT) identify the etiological agent well as provide information about drug resistance in a couple of days or even hours upon receipt of the specimen. PCR is the common format of NAAT other methodologies include; ligase chain reaction, strain displacement amplification, loop-mediated isothermal amplification (LAMP), and transcription-mediated amplification.
Molecular tests that detect mutations in genes provide information about drug resistance;
- Catalase gene (mediates resistance to isoniazid),
- RNA polymerase gene (mediates resistance to rifampin).
Xpert MTB/RIF assay

GeneXpert MTB/RIF assay is a nucleic acid amplification test which simultaneously detects DNA ofMycobacterium tuberculosiscomplex (MTBC) and resistance to rifampin (RIF)(i.e. mutation of the rpoB gene) in less than 2 hours.
Find more about Xpert MTB/RIF assay
Antigen detection methods
MTB antigen detection provides direct evidence of TB. Lipoarabinomannan (LAM) is a promising target for antigen detection for TB diagnosis and is used for the rapid detection of tubercle bacilli in a variety of body fluids, including urine. Besides that, the detection of other antigens such as 65 Kd and 14 Kd antigens are also widely used.
Indirect methods for the detection of MTB
It includes the detection of immune response by tuberculin skin testing (TST) and interferon-gamma release assays (IGRAs). These tests are positive in both latent disease and in active tuberculosis so any person with a positive test must be evaluated for the presence of active disease.
Tuberculin skin test or PPD test

The PPD (purified protein derivative) test determines if someone has developed an immune response to MTB. This response can occur if someone currently has TB, if they were exposed to it in the past, or if they received the BCG vaccination. The standard recommended tuberculin test is the Mantoux test, in which a 0.1 mL of liquid containing 5 TU (tuberculin units) PPD is injected into the top layers of skin of the forearm and observed for presence or absence and the amount of induration (localized swelling) within 48-72 hours after the injection.
You may like to check:Tuberculin Skin Test (Mantoux test): Principle, Procedure, Results, and Limitations
Interferon-Gamma Release Assays (IGRA)

The interferon-gamma assay overcomes the difficulties faced with the tuberculin test interpretation. Two available formats of the interferon-gamma release assays are; the Quantiferon-TB Gold and T Spot-TB test. The IGRA assay is based on the ability of the MTB antigens, such as Early Secretory Antigen Target 6 (ESAT-6) and Culture Filtrate Protein 10 (CFP-10) to stimulate the host for the production of interferon-gamma (IFN-Îł).
The amount of interferon-Îł released from the cells is measured. Results are interpreted both qualitatively (positive, negative, or indeterminate) and quantitatively. BCG immunization does not affect the test result of IGRA assay, as the antigens used here are specific for Mycobacterium tuberculosis and are not present in BCG vaccine.
References and further readings
- Tille, P. (2017). Bailey & Scott’s Diagnostic Microbiology (14 edition). Mosby.
- Procop, G. W., & Koneman, E. W. (2016). Koneman’s Color Atlas and Textbook of Diagnostic Microbiology(Seventh, International edition). Lippincott Williams and Wilkins.